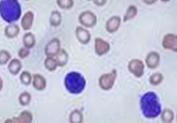
急性骨髓性白血病

急性骨髓性白血病(Acute myeloid leukemia,AML),是一種骨髓性白細胞(而非淋巴性白細胞)異常增殖的血癌。其特點是骨髓內(nèi)異常細胞的快速增殖而影響了正常血細胞的產(chǎn)生。急性骨髓性白血病是成年人最常見的急性白血病,其發(fā)病率隨著人的年齡而增加。急性骨髓性白血病還是比較罕見的疾病,在美國約占因癌癥而死亡的人數(shù)的1.2%。
- 外文名:
- 就診科室:血液內(nèi)科
- 傳染性:無
- 多發(fā)群體:
- 常見病因:
- 常見癥狀:面色蒼白、發(fā)熱、身困無力、伴心悸氣短、胸脅壓痛、關(guān)節(jié)疼、皮膚呈現(xiàn)少量致密出血點、淋巴結(jié)腫大、
- 人氣指數(shù): 人
- 更新日期:2023.11.24 09:29
- 疾病介紹
疾病標簽:
-
急性骨髓性白血病,急性骨髓性白血病癥狀,急性骨
相關(guān)疾病
-
梅勒尼壞疽
628健康網(wǎng)為您分享有關(guān)梅勒尼壞疽的癥狀,梅勒尼壞疽的治療方法,梅勒尼壞疽的預(yù)防知識,梅勒尼壞疽的癥狀圖片,梅勒尼壞疽...
-
地中海貧血
628健康網(wǎng)為您分享有關(guān)地中海貧血的癥狀,地中海貧血的治療方法,地中海貧血的預(yù)防知識,地中海貧血的癥狀圖片,地中海貧血...
-
微小病毒感染
628健康網(wǎng)為您分享有關(guān)微小病毒感染的癥狀,微小病毒感染的治療方法,微小病毒感染的預(yù)防知識,微小病毒感染的癥狀圖片,微...
-
巨球蛋白血癥
628健康網(wǎng)為您分享有關(guān)巨球蛋白血癥的癥狀,巨球蛋白血癥的治療方法,巨球蛋白血癥的預(yù)防知識,巨球蛋白血癥的癥狀圖片,巨...
版權(quán)聲明:
1、本站內(nèi)容僅做參考,不能作為診斷及醫(yī)療的依據(jù)!
2、本文內(nèi)容來源于網(wǎng)絡(luò)或會員發(fā)布,版權(quán)歸原網(wǎng)站所有。
3、本站僅提供信息展示,不承擔相關(guān)法律責任。





